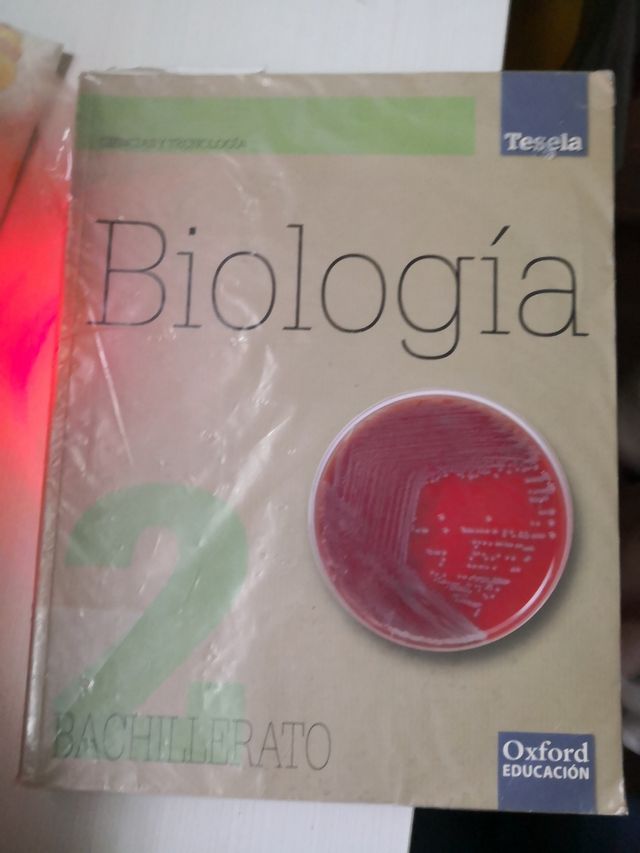
Libro biología 2 bachillerato Oxford

Alice A.
21 Ventas1 Compra
1 Envío
28850, Base Aerea Conjunta Torrejon
- 25 €
Jardínes eternos y kokedamas
- 5 €
falda con cola stradivarius
- 5 €
Short bañador chica
- 10 €
bañador unisex john smith
- 8 €
cortavientos running
- 20 €
Camiseta Adidas rayas blancas y negras
- 12 €
vestido nochevieja
- 8 €
sudadera mujer
- 7 €
jersey animal print
- 10 €
botas punta acero nuevas n°37
10 €vestido
- 10 €
pijama zara niño de 1 a 2 años a estrenar
- 5 €
vestido ajustado
- 6 €
pantalon recto rosa palo
- 5 €
Short bañador unisex
8 €camisa pedro del hierro casi nueva
- 10 €
falda larga
5 €Americana mujer
15 €Camisa
- 5 €
vestido
- 5 €
legging vaquero flores
- 4,50 €
top lentejuelas
5 €Vestido
6 €camiseta
- 5 €
top pimkie talla S
- 15 €
lamparita
5 €Vestido
- 14 €
sudadera Adidas mujer
- 10 €
sudadera mujer formula joven
- 6 €
camisa vestir
- 6 €
bolsa térmicas portátil
- 10 €
vaquero mujer recto
- 8 €
vestido vintage primavera
- 7 €
vestido
- 15 €
libro matemáticas 1°bachillerato
- 12 €
chaleco pelo con capucha
- 10 €
Libro 2 bachillerato física
- 10 €
jerseys super suave manga ancha
- 10 €
Libro biología 2 bachillerato Oxford
- 10 €
Libro matemáticas 2 bachillerato